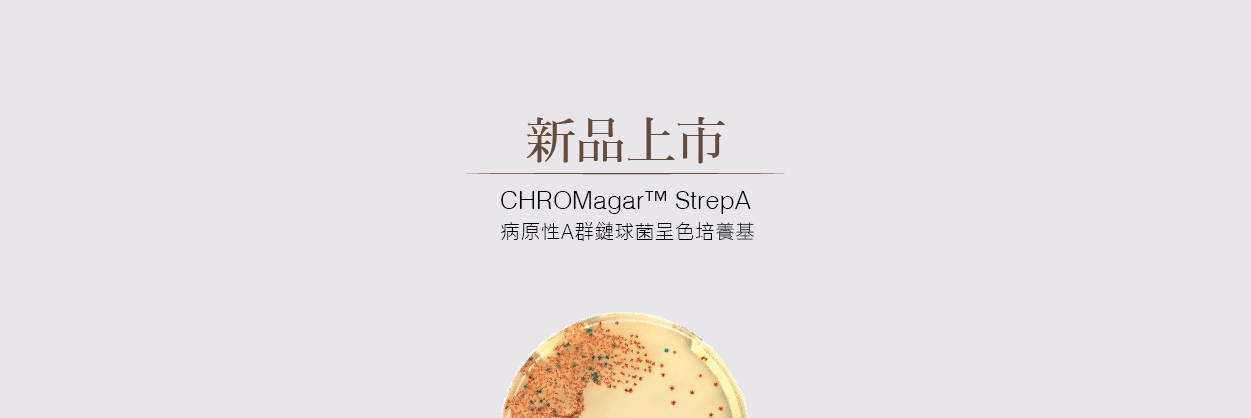
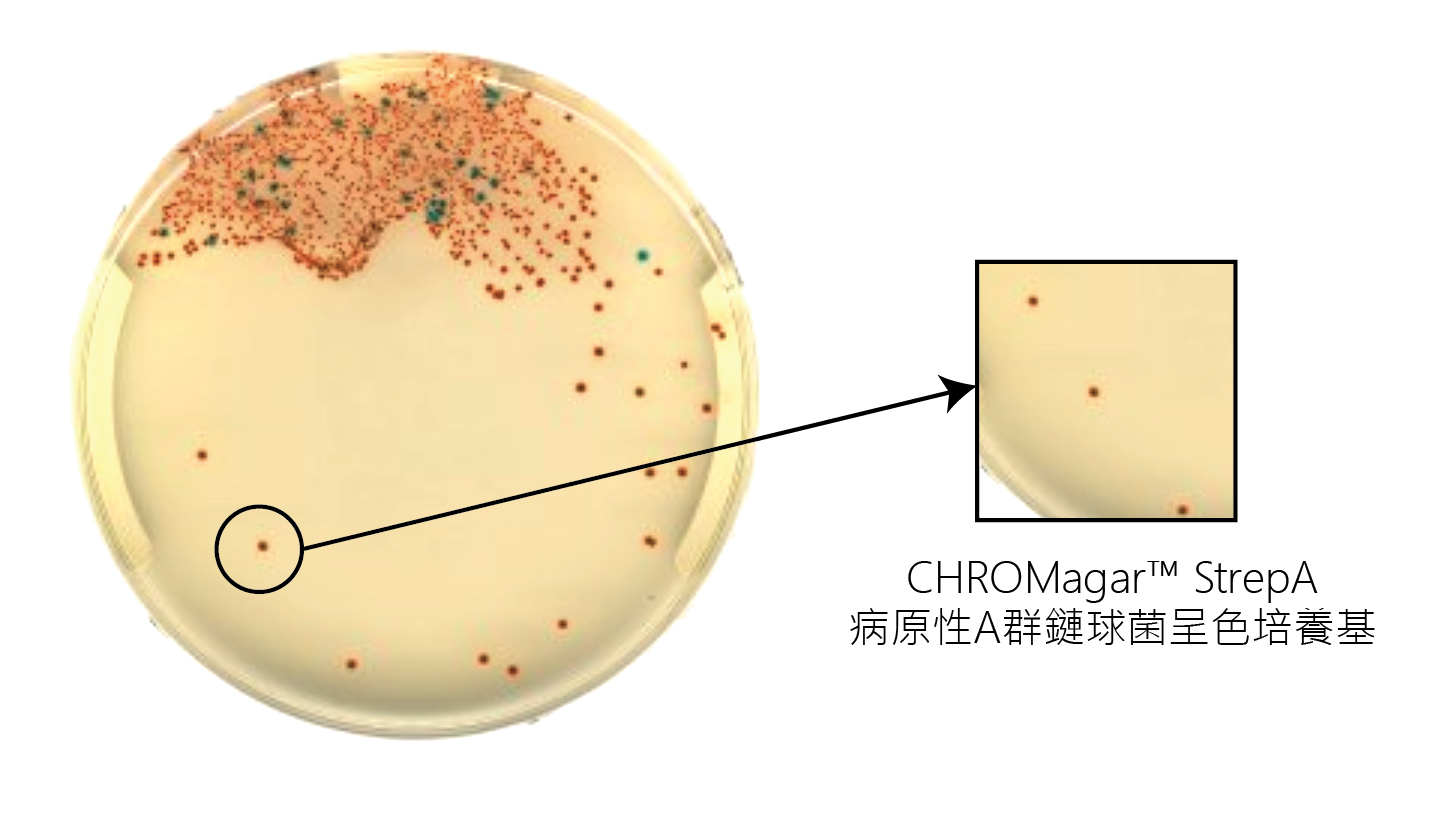

2019/07/10 新品上市-科瑪嘉 CHROMagar™ StrepA /病原性A群鏈球菌呈色培養基
|
CHROMagar™ StrepA 病原性A群鏈球菌呈色培養基 產品特色 CHROMagarTM StrepA 鏈球菌是一種新的呈色基質配方,可以在咽喉檢體複雜菌群中,輕易地由顏色直接判定,病原性A群鏈球菌(GAS)菌落(由橙色到紅色)或其他鏈球菌(無色或藍色菌落)
聚焦於病原性鏈球菌 細菌性咽喉炎主要是由病原性鏈球菌是引起的,因此,目前主要篩選鏈球菌方式以鼻咽喉部位拭子為主。 在咽喉拭子檢體中,可快速準確地檢測病原性鏈球菌,特別對兒童和老年患者及抗生素治療、預防併發症和降低傳染給其他人的風險至關重要。 患者通常使用抗原檢測GAS是否存在,約15-20 分鐘可以提供初步結果,陽性率為70-90%,偽陰性有10-20%。無論如何,最終結果需要24小時的咽喉培養進行確認。 |
詳細資料請連結:科瑪嘉 CHROMagar StrepA 培養基













